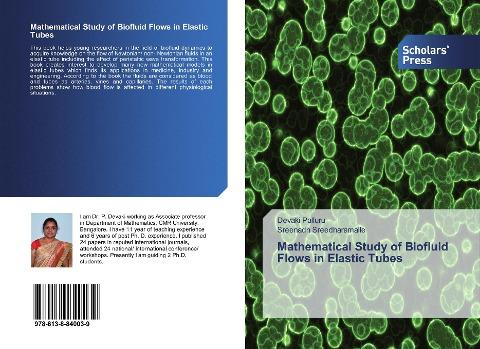
Mathematical Study of Biofluid Flows in Elastic Tubes

Autorenfreundlich Bücher kaufen?!

Beschreibung
This book helps young researchers in the field of biofluid dynamics to acquire knowledge on the flow of Newtonian/ non- Newtonian fluids in an elastic tube including the effect of peristaltic wave transformation. This book creates interest to develop many new mathematical models in elastic tubes which finds its applications in medicine, industry and engineering. According to the book the fluids are considered as blood and tubes as arteries, vines and capillaries. The results of each problems show how blood flow is affected in different physiological situations.
Details
| Verlag | Scholars' Press |
| Ersterscheinung | 16. Juli 2019 |
| Maße | 22 cm x 15 cm x 0.7 cm |
| Gewicht | 173 Gramm |
| Format | Softcover |
| ISBN-13 | 9786138840039 |
| Seiten | 104 |
